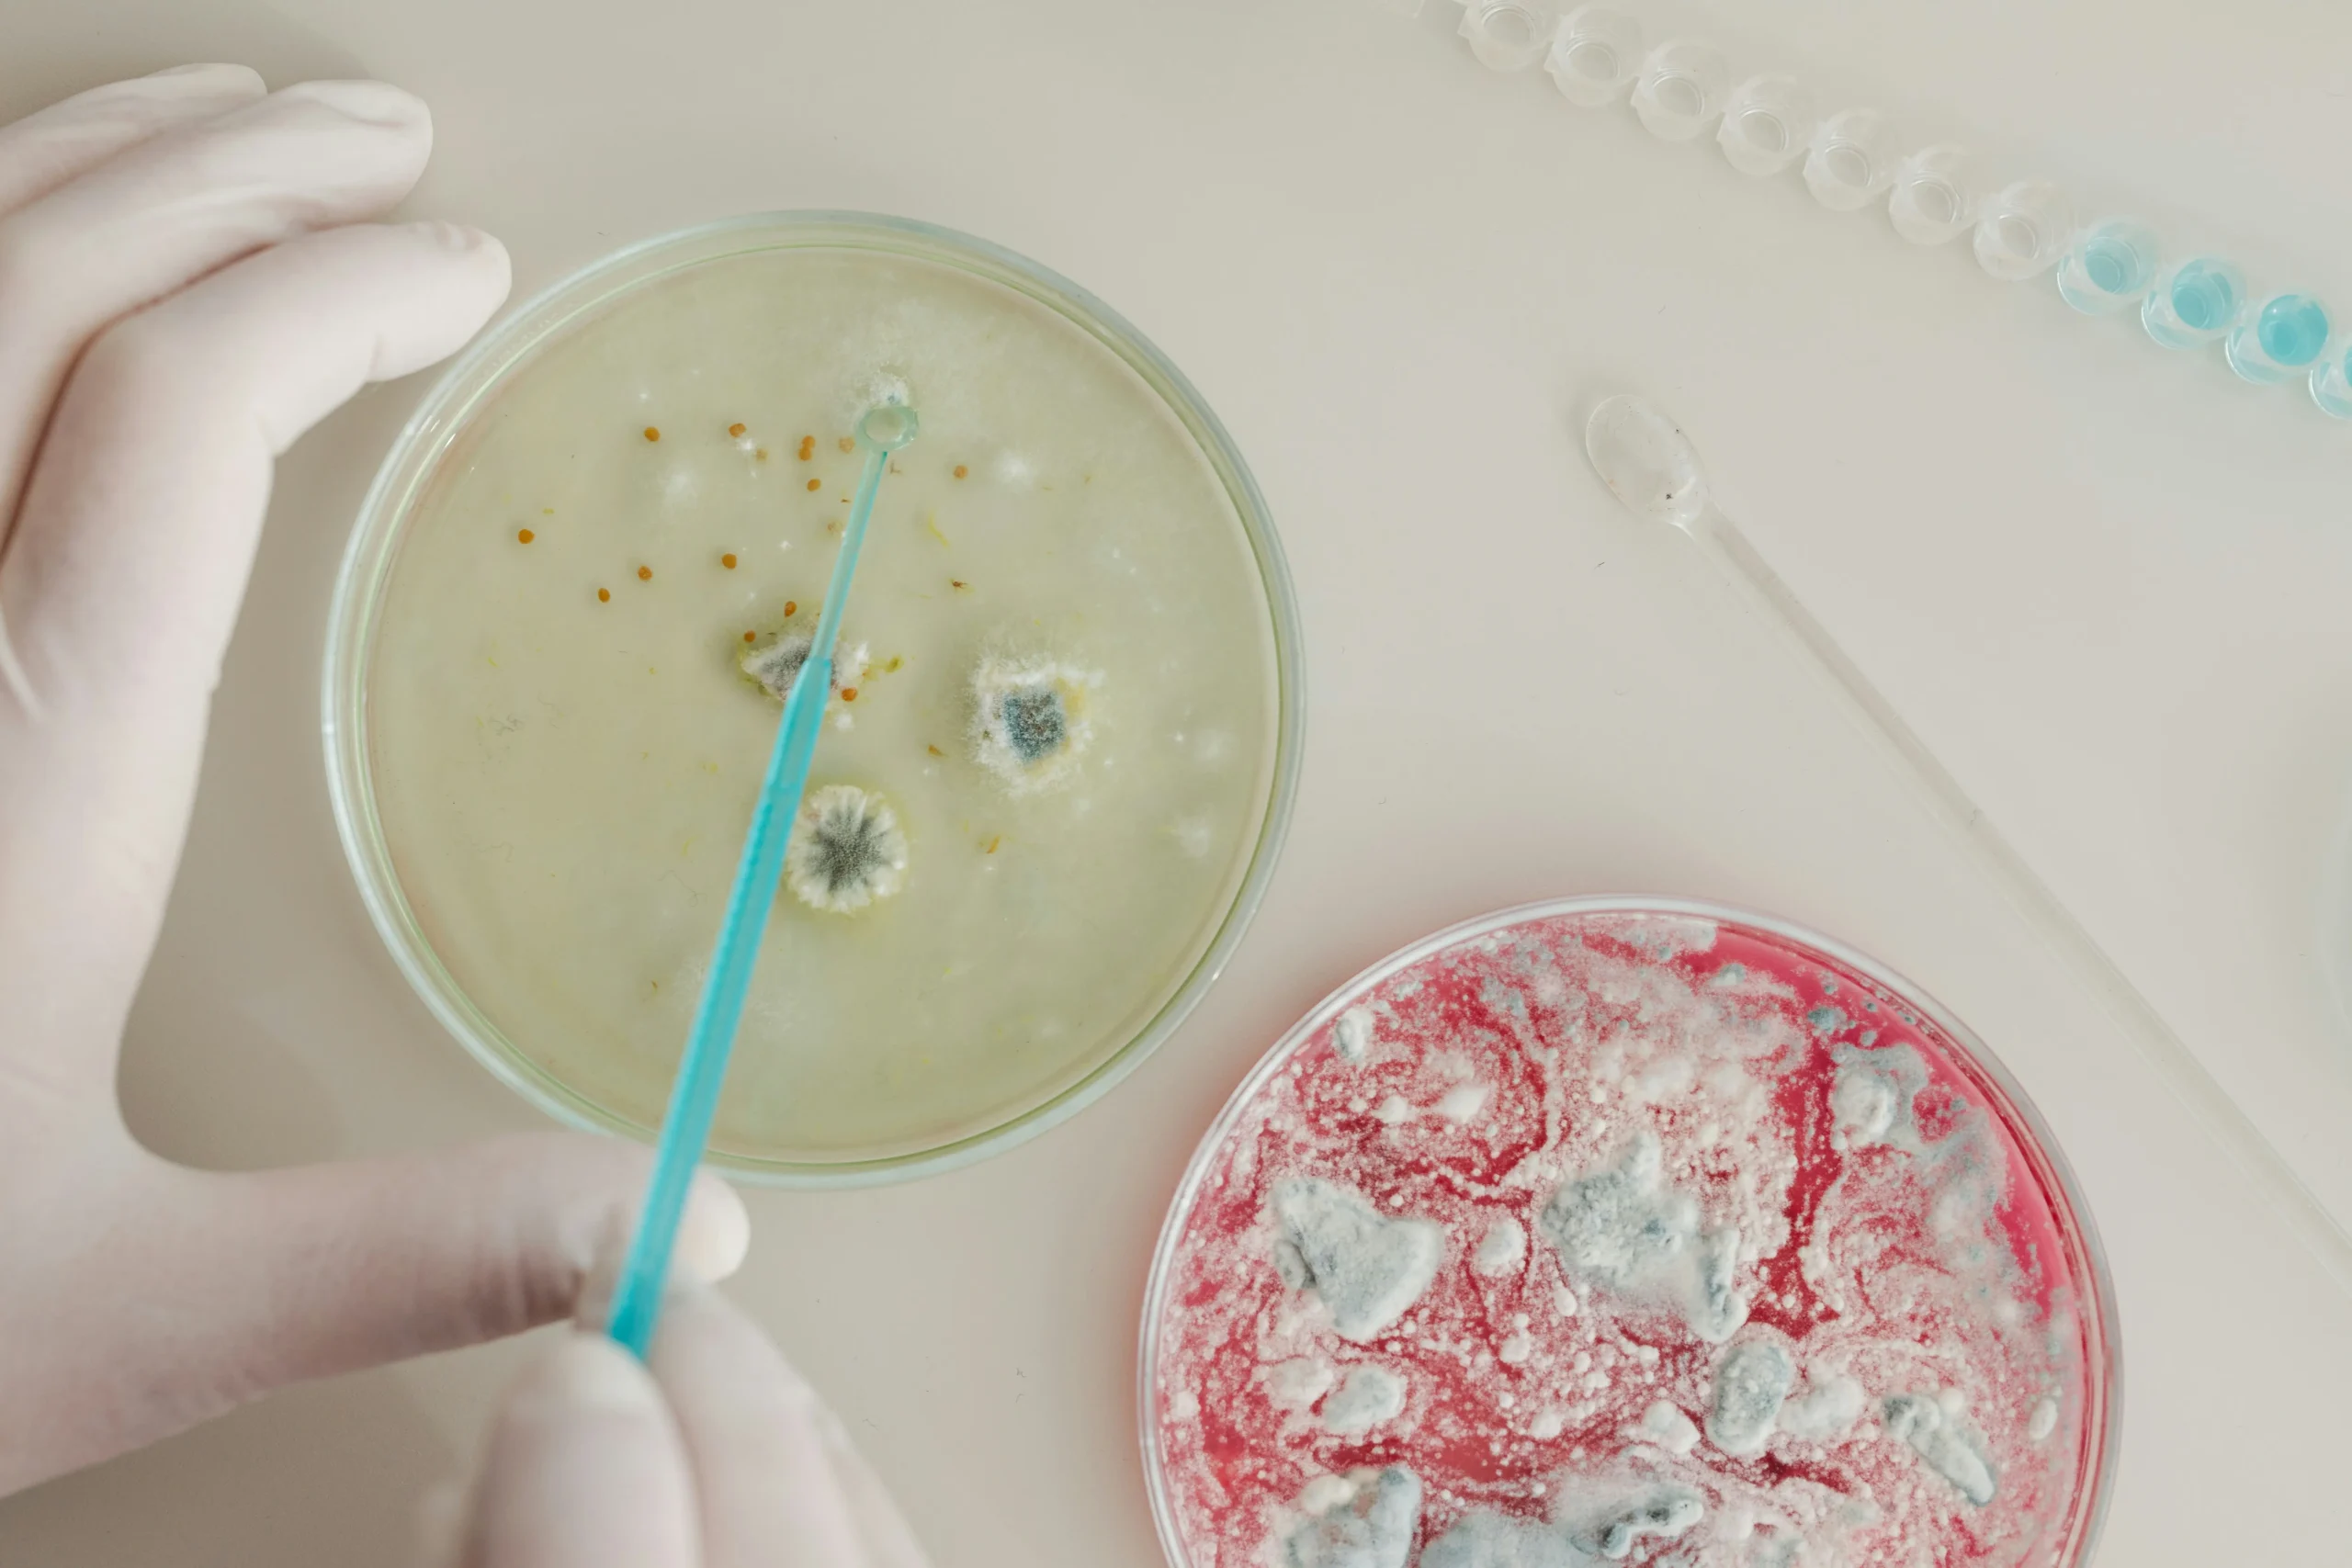

Because where others see obstacles, you need opportunity.
The life sciences industry is growing fast – but so are the hiring challenges. As pharmaceutical, biotech, and MedTech companies continue to innovate, the pressure to attract and retain top-tier talent has never been greater.
At Axion, we work at the heart of this challenge every day. Here’s what we’re seeing across the market – and how leading organisations are adapting to stay ahead.
1. Talent shortages in highly specialised roles
The demand for niche expertise is outpacing supply. Whether it’s experienced Regulatory Affairs professionals, Clinical Development leaders, or Biostatistics experts – these individuals are in short supply and high demand.
Many of the best candidates aren’t actively job hunting. They’re settled, successful, and highly selective about the roles they consider.
How to overcome it:
You need a search strategy that goes far beyond job adverts. That means proactive headhunting, deep talent mapping, and engaging with passive candidates long before they’re ready to move. It also means working with a specialist recruitment partner who already knows the key players in your space – and can make the right introductions, fast.
2. Lengthy, inefficient hiring processes
In a competitive market, speed matters. The most sought-after candidates won’t wait through a four-stage interview process or delays in decision-making. A slow or disjointed hiring experience can result in losing top talent to more agile competitors.
How to overcome it:
Streamline your process. Define clear timelines, ensure internal alignment, and communicate transparently with candidates from start to finish. Partnering with a recruitment specialist can help you identify bottlenecks and introduce efficiencies without compromising on quality or compliance.
3. Rising competition from global life sciences hubs
As life sciences becomes more globally connected, your competition isn’t just local – it’s international. Candidates now have more options, including fully remote roles, relocation opportunities, and competitive offers from multinational giants.
How to overcome it:
You need to lead with more than just salary. Highlight your mission, your culture, and your impact. Employer branding plays a critical role here – candidates want to feel connected to your purpose, not just your pay package. If you’re a start-up or scale-up, position yourself as an innovation-led environment where people can truly make a difference.
4. Meeting compliance and regulatory requirements
Hiring in pharma and biotech isn’t just about capability – it’s about compliance. Roles often require highly specific qualifications, documentation, and a deep understanding of regulatory frameworks across multiple regions.
How to overcome it:
Ensure your recruitment processes are built with compliance in mind. From right-to-work checks and background screening to sector-specific regulatory requirements, precision matters. Partner with a recruiter who understands the regulatory environment and integrates compliance into every stage of the search.
5. Building diverse and inclusive teams
Diversity drives innovation – but creating diverse shortlists in a specialised, often male-dominated industry isn’t straightforward. Many organisations struggle to balance experience requirements with inclusive hiring goals.
How to overcome it:
Re-examine how and where you’re sourcing talent. Look beyond the usual networks. Ensure your job descriptions and employer brand messaging are inclusive and accessible. Work with a partner who actively prioritises diverse representation in search processes and can advise on long-term inclusion strategies.
Turn challenge into competitive advantage
The hiring landscape in life sciences is evolving – but the companies who adapt fastest are the ones who win the best people. It’s not about casting the widest net – it’s about using the right approach, in the right places, with the right support.
At Axion, we specialise in solving complex hiring challenges for forward-thinking life sciences companies. From strategic talent planning to accessing hard-to-reach candidates, we help you overcome obstacles – and find the people who will drive your business forward.